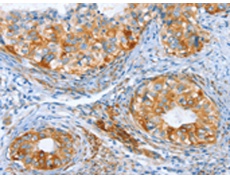
一抗

中文名稱:兔抗AIP多克隆抗體
英文名稱: Anti-AIP rabbit polyclonal antibody
別 名: ARA9; XAP2; XAP-2; FKBP16; FKBP37; SMTPHN
相關類別: 一抗
儲 存: 冷凍(-20℃)
宿 主: Rabbit
抗 原: AIP
反應種屬: Human, Mouse, Rat
標 記 物: Unconjugate
克隆類型: rabbit polyclonal
技術規格
|
Background: |
The protein encoded by this gene is a receptor for aryl hydrocarbons and a ligand-activated transcription factor. The encoded protein is found in the cytoplasm as part of a multiprotein complex, but upon binding of ligand is transported to the nucleus. This protein can regulate the expression of many xenobiotic metabolizing enzymes. Also, the encoded protein can bind specifically to and inhibit the activity of hepatitis B virus. |
|
Applications: |
ELISA, IHC |
|
Name of antibody: |
AIP |
|
Immunogen: |
Synthetic peptide of human AIP |
|
Full name: |
aryl hydrocarbon receptor interacting protein |
|
Synonyms: |
ARA9; XAP2; XAP-2; FKBP16; FKBP37; SMTPHN |
|
SwissProt: |
O00170 |
|
ELISA Recommended dilution: |
2000-10000 |
|
IHC positive control: |
Human cervical cancer and Human thyroid cancer |
|
IHC Recommend dilution: |
100-300 |

 購物車
購物車 幫助
幫助
 021-54845833/15800441009
021-54845833/15800441009